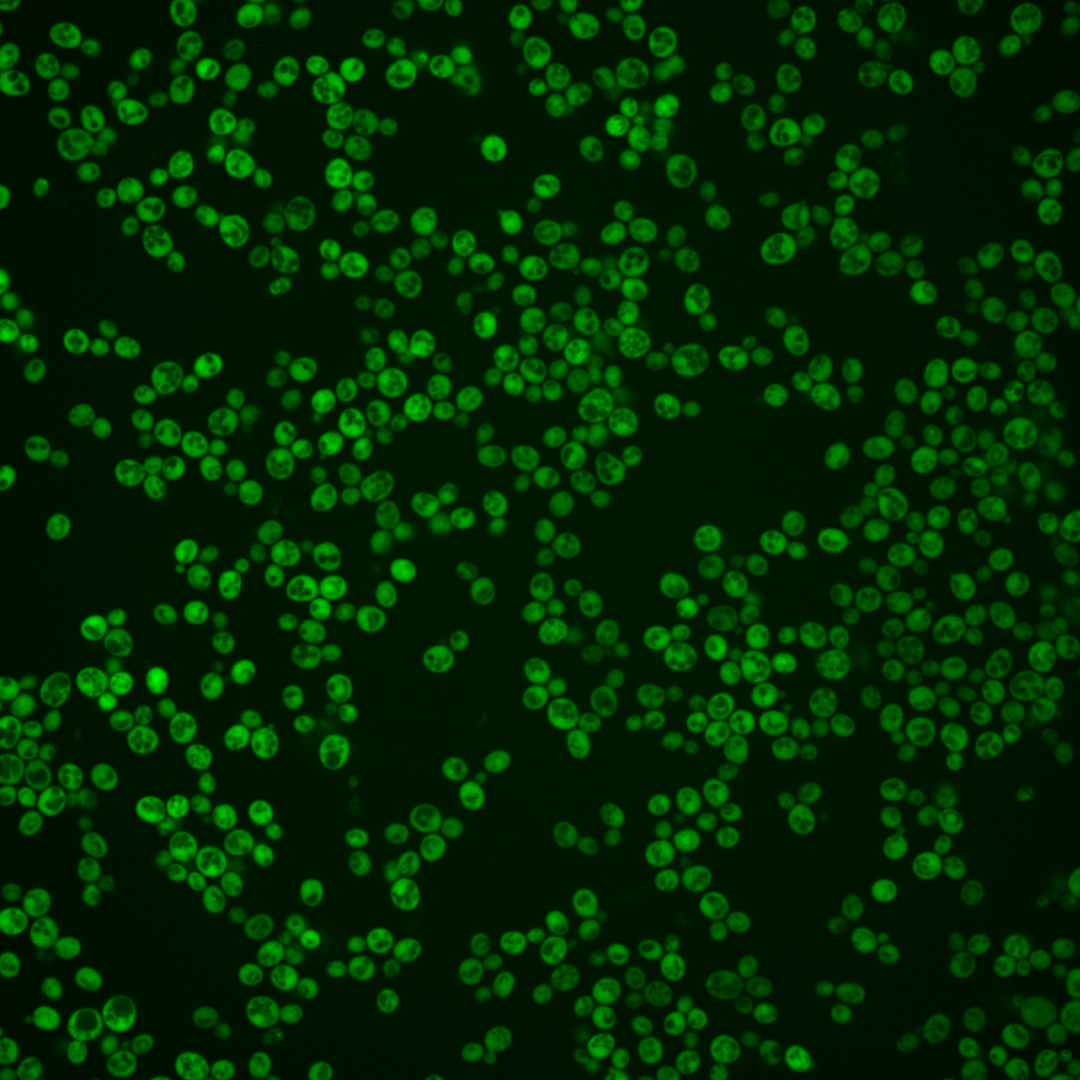
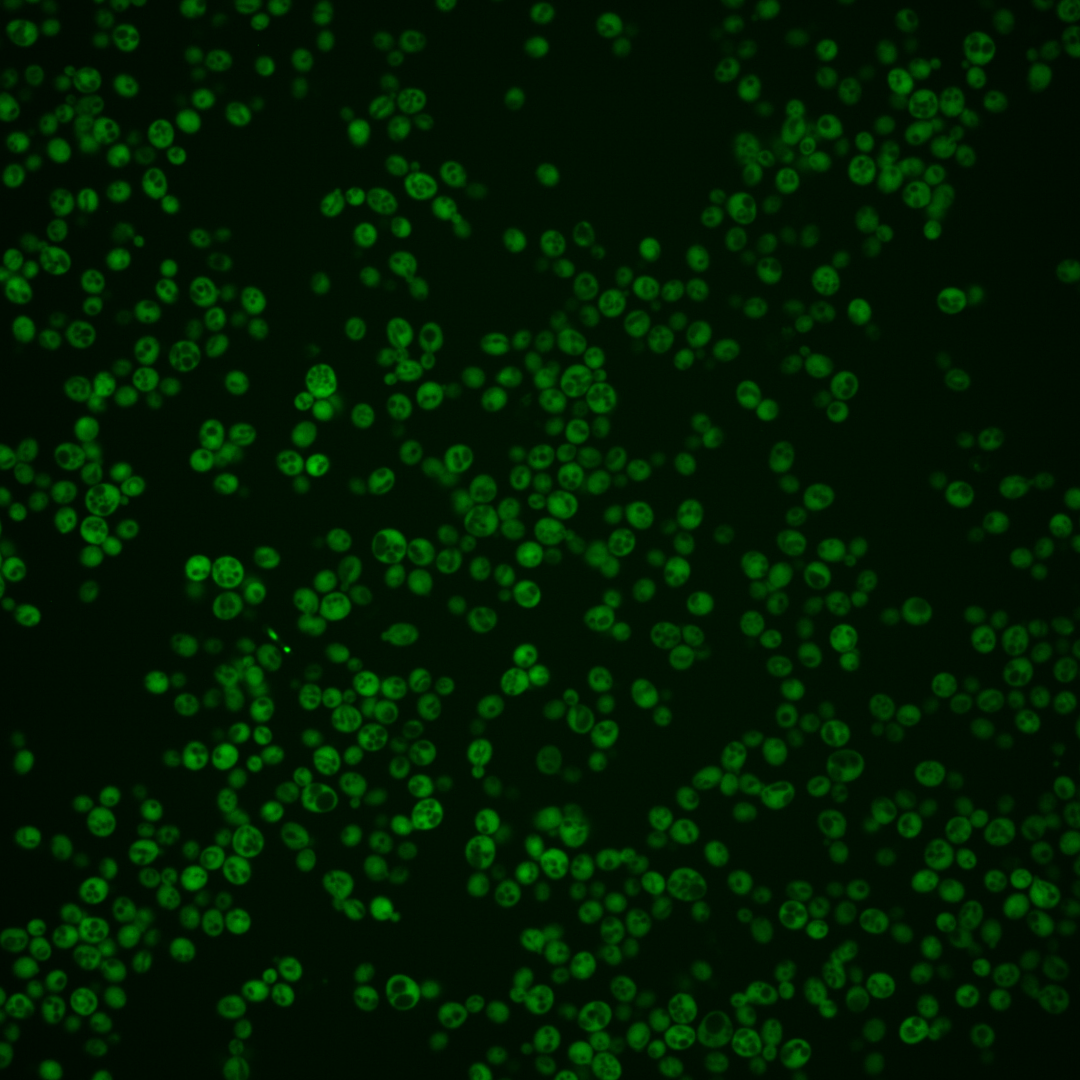
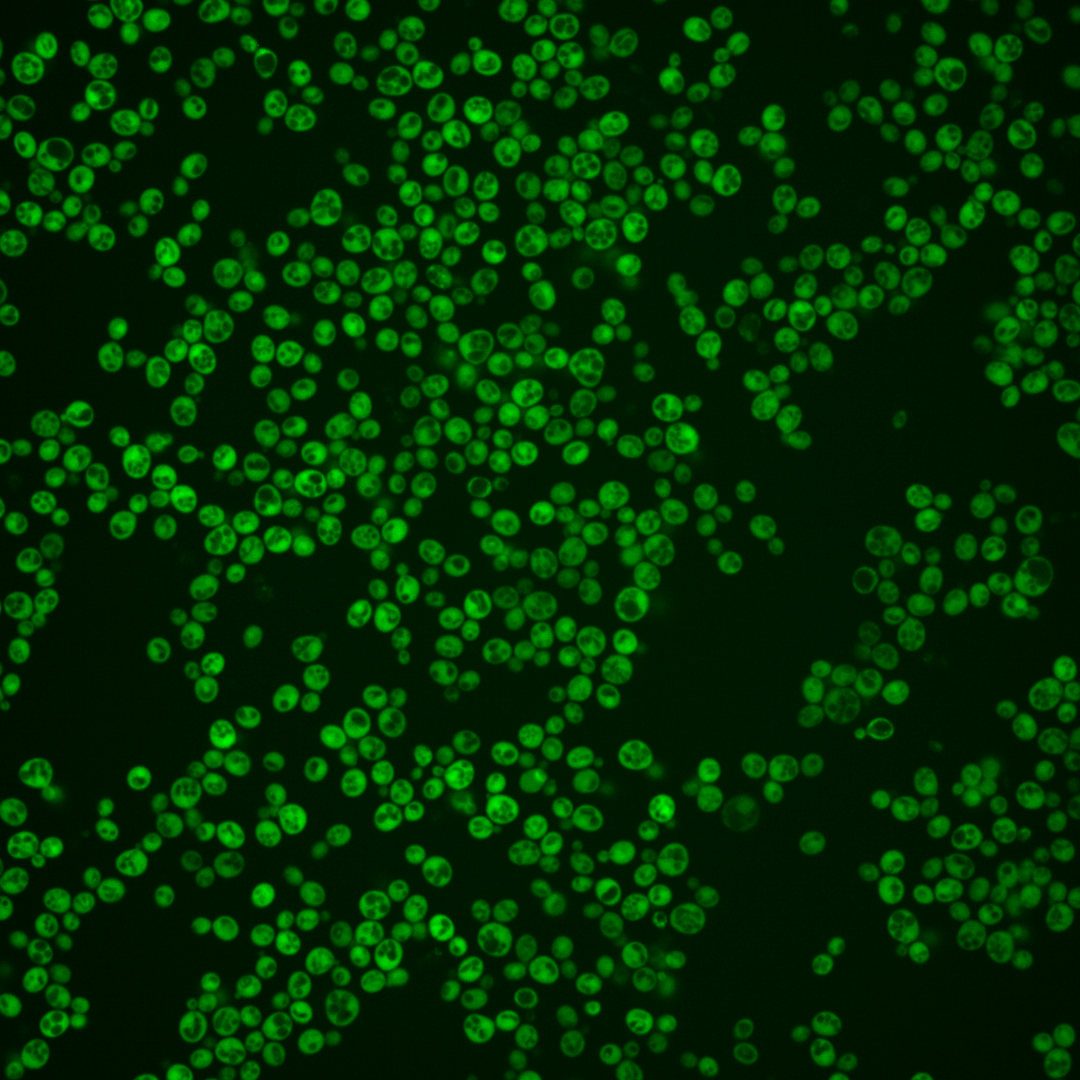
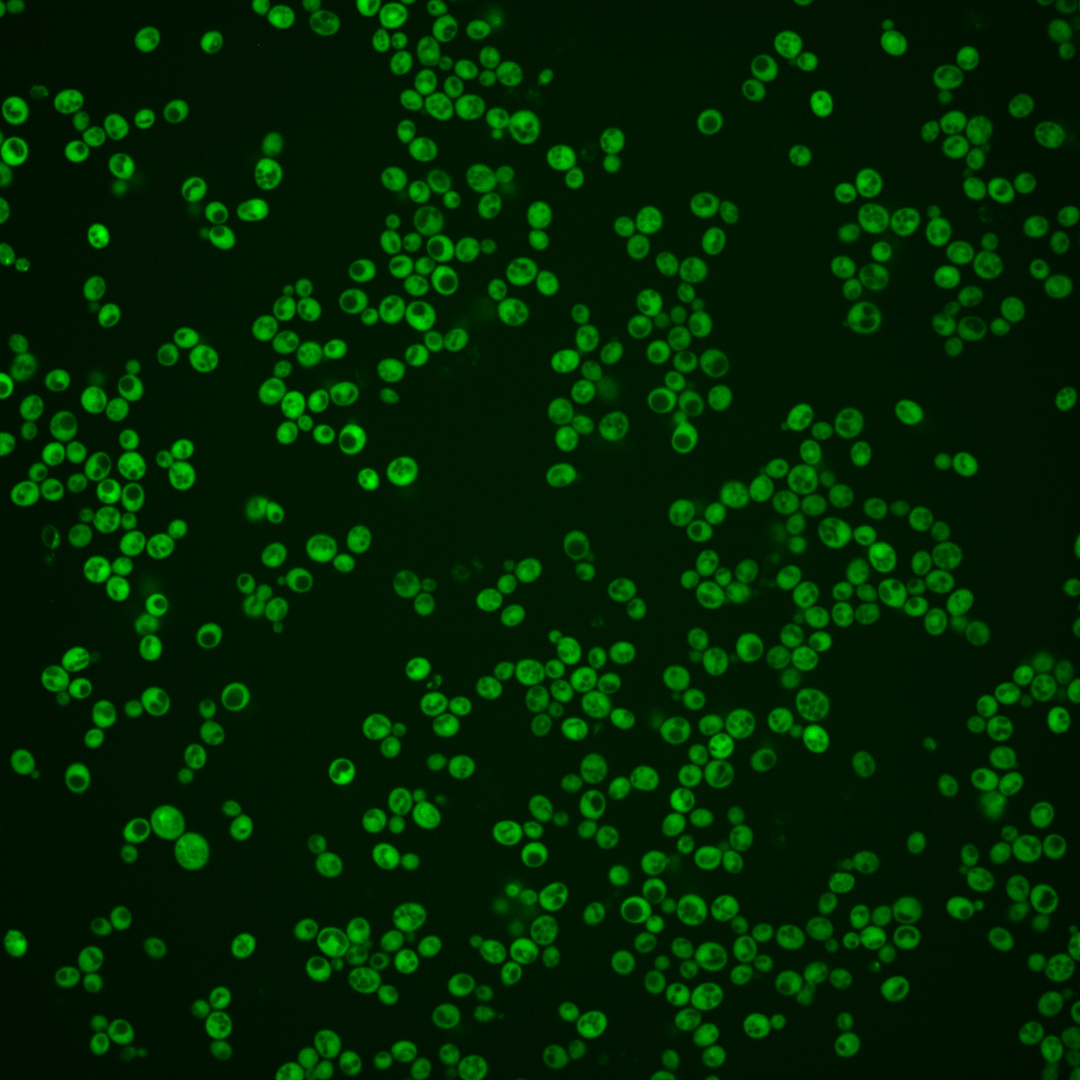
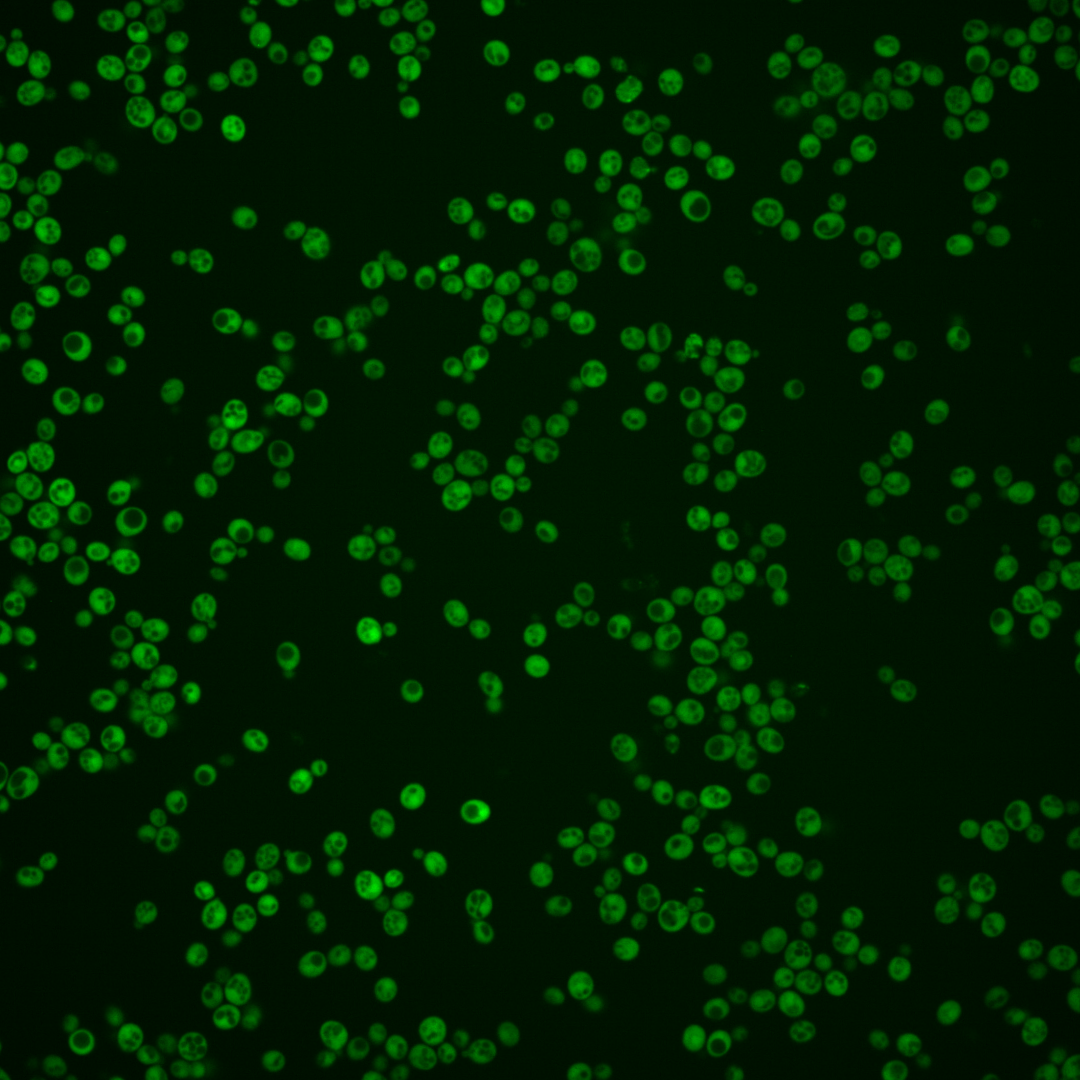
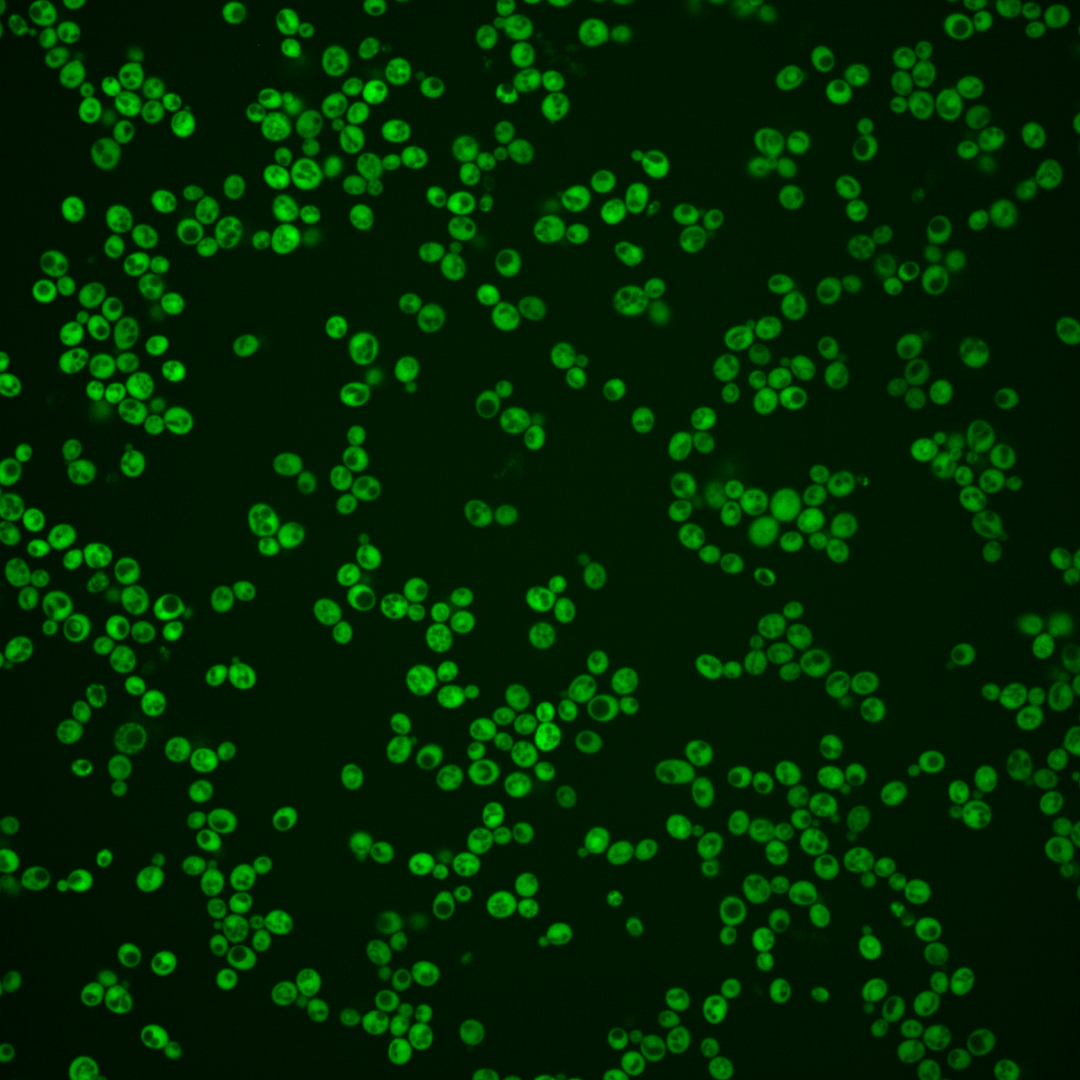
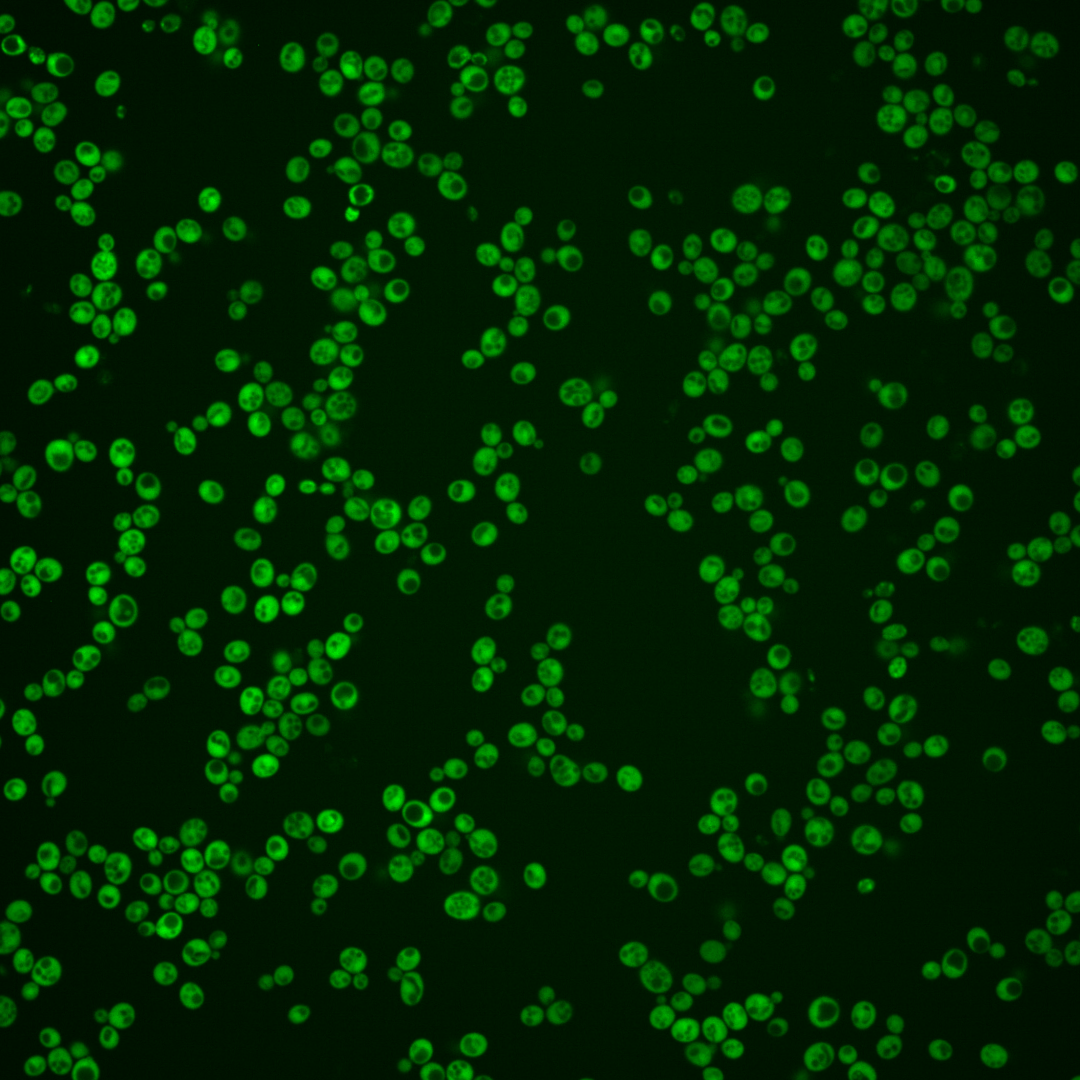

| Standard name | |
|---|---|
| Human Ortholog | |
| Description | Adenine phosphoribosyltransferase; catalyzes the formation of AMP from adenine and 5-phosphoribosylpyrophosphate; involved in the salvage pathway of purine nucleotide biosynthesis; APT1 has a paralog, APT2, that arose from the whole genome duplication |
Micrographs




















































































Sub-cellular Localization
Yeast GFP Assignment
Protein Abundance
Localization Change
External localization resources
| ensLOC | DeepLoc | |||||||||||||||||||||||
|---|---|---|---|---|---|---|---|---|---|---|---|---|---|---|---|---|---|---|---|---|---|---|---|---|
| Localization | WT1 | WT2 | WT3 | RAP60 | RAP140 | RAP220 | RAP300 | RAP380 | RAP460 | RAP540 | RAP620 | RAP700 | HU80 | HU120 | HU160 | rpd3Δ_1 | rpd3Δ_2 | rpd3Δ_3 | WT1 | WT2 | WT3 | AF100 | AF140 | AF180 |
| Cortical Patches | 0 | 0 | 0 | 0 | 0 | 0 | 0 | – | 0 | 0 | 0 | 0 | 0 | 0 | 0 | 0 | 0 | 0 | 2 | 1 | 0 | 2 | 2 | 1 |
| Bud | 0 | 1 | 0 | 0 | 0 | 2 | 0 | – | 1 | 3 | 2 | 1 | 0 | 0 | 0 | 0 | 0 | 0 | 3 | 3 | 0 | 2 | 11 | 13 |
| Bud Neck | 0 | 0 | 0 | 0 | 0 | 0 | 0 | – | 0 | 0 | 0 | 0 | 0 | 0 | 0 | 0 | 0 | 0 | 0 | 1 | 0 | 0 | 1 | 1 |
| Bud Site | 0 | 0 | 0 | 0 | 0 | 0 | 0 | – | 0 | 0 | 0 | 0 | 0 | 0 | 0 | 0 | 0 | 0 | – | – | – | – | – | – |
| Cell Periphery | 4 | 2 | 1 | 1 | 3 | 0 | 5 | – | 6 | 11 | 2 | 0 | 1 | 3 | 10 | 3 | 8 | 4 | 0 | 0 | 0 | 0 | 0 | 0 |
| Cytoplasm | 262 | 371 | 87 | 81 | 103 | 119 | 163 | – | 144 | 167 | 85 | 54 | 359 | 582 | 658 | 216 | 174 | 200 | 254 | 357 | 98 | 348 | 520 | 510 |
| Endoplasmic Reticulum | 1 | 0 | 1 | 0 | 0 | 1 | 5 | – | 2 | 8 | 0 | 1 | 1 | 2 | 4 | 11 | 6 | 3 | 0 | 0 | 2 | 3 | 5 | 4 |
| Endosome | 2 | 0 | 0 | 0 | 0 | 0 | 0 | – | 0 | 1 | 0 | 0 | 0 | 0 | 0 | 0 | 0 | 0 | 1 | 0 | 0 | 0 | 0 | 0 |
| Golgi | 1 | 0 | 0 | 0 | 0 | 0 | 0 | – | 0 | 0 | 0 | 0 | 0 | 0 | 0 | 0 | 1 | 1 | 0 | 1 | 0 | 0 | 0 | 0 |
| Mitochondria | 1 | 0 | 0 | 2 | 1 | 16 | 4 | – | 24 | 35 | 26 | 23 | 0 | 0 | 0 | 2 | 1 | 2 | 0 | 0 | 0 | 0 | 0 | 1 |
| Nucleus | 5 | 2 | 4 | 0 | 1 | 3 | 4 | – | 4 | 11 | 6 | 2 | 4 | 6 | 6 | 0 | 0 | 0 | 1 | 2 | 2 | 0 | 0 | 3 |
| Nuclear Periphery | 0 | 0 | 0 | 1 | 0 | 1 | 0 | – | 0 | 0 | 0 | 5 | 1 | 0 | 0 | 0 | 0 | 0 | 2 | 0 | 0 | 1 | 2 | 1 |
| Nucleolus | 0 | 0 | 0 | 0 | 0 | 0 | 0 | – | 0 | 0 | 0 | 2 | 0 | 0 | 0 | 0 | 1 | 0 | 0 | 0 | 0 | 0 | 0 | 0 |
| Peroxisomes | 0 | 0 | 0 | 0 | 0 | 0 | 0 | – | 0 | 0 | 0 | 0 | 0 | 0 | 0 | 0 | 0 | 0 | 0 | 0 | 0 | 0 | 0 | 0 |
| SpindlePole | 0 | 0 | 0 | 0 | 0 | 0 | 0 | – | 0 | 0 | 0 | 0 | 0 | 0 | 0 | 0 | 0 | 0 | 0 | 0 | 0 | 0 | 1 | 2 |
| Vac/Vac Membrane | 5 | 0 | 3 | 2 | 3 | 11 | 32 | – | 25 | 30 | 10 | 10 | 3 | 7 | 7 | 2 | 4 | 3 | 1 | 2 | 0 | 4 | 3 | 4 |
| Unique Cell Count | 271 | 372 | 93 | 85 | 107 | 136 | 201 | 186 | 240 | 119 | 85 | 364 | 594 | 675 | 221 | 180 | 205 | 270 | 373 | 108 | 367 | 556 | 547 | |
| Labelled Cell Count | 281 | 376 | 96 | 87 | 111 | 153 | 213 | 206 | 266 | 131 | 98 | 369 | 600 | 685 | 234 | 195 | 213 | 270 | 373 | 108 | 367 | 556 | 547 | |
Yeast GFP Assignment
Protein Abundance
| Screen | WT1 | WT2 | WT3 | RAP60 | RAP140 | RAP220 | RAP300 | RAP380 | RAP460 | RAP540 | RAP620 | RAP700 | HU80 | HU120 | HU160 | rpd3Δ_1 | rpd3Δ_2 | rpd3Δ_3 | AF100 | AF140 | AF180 |
|---|---|---|---|---|---|---|---|---|---|---|---|---|---|---|---|---|---|---|---|---|---|
| Mean Cell GFP Intensity (1e-4) | 20.4 | 18.0 | 18.0 | 14.6 | 14.8 | 8.1 | 10.2 | – | 8.1 | 8.1 | 7.1 | 6.8 | 17.5 | 16.8 | 16.4 | 23.8 | 25.1 | 22.9 | 18.0 | 17.9 | 18.1 |
| Std Deviation (1e-4) | 6.0 | 4.5 | 4.5 | 4.4 | 3.6 | 2.6 | 2.2 | – | 1.8 | 1.8 | 1.8 | 1.4 | 4.7 | 4.1 | 4.0 | 5.4 | 5.8 | 5.8 | 4.7 | 5.1 | 5.2 |
| Intensity Change (Log2) | – | – | – | -0.3 | -0.28 | -1.15 | -0.83 | – | -1.15 | -1.15 | -1.35 | -1.41 | -0.04 | -0.11 | -0.14 | 0.4 | 0.48 | 0.34 | -0.01 | -0.01 | 0.0 |
Localization Change
| Localization | RAP60 | RAP140 | RAP220 | RAP300 | RAP380 | RAP460 | RAP540 | RAP620 | RAP700 | HU80 | HU120 | HU160 | rpd3Δ_1 | rpd3Δ_2 | rpd3Δ_3 |
|---|---|---|---|---|---|---|---|---|---|---|---|---|---|---|---|
| Cortical Patches | 0 | 0 | 0 | 0 | – | 0 | 0 | 0 | 0 | 0 | 0 | 0 | 0 | 0 | 0 |
| Bud | 0 | 0 | 0 | 0 | – | 0 | 0 | 0 | 0 | 0 | 0 | 0 | 0 | 0 | 0 |
| Bud Neck | 0 | 0 | 0 | 0 | – | 0 | 0 | 0 | 0 | 0 | 0 | 0 | 0 | 0 | 0 |
| Bud Site | 0 | 0 | 0 | 0 | – | 0 | 0 | 0 | 0 | 0 | 0 | 0 | 0 | 0 | 0 |
| Cell Periphery | 0 | 0 | 0 | 0 | – | 0 | 0 | 0 | 0 | 0 | 0 | 0 | 0 | 0 | 0 |
| Cytoplasm | 0.5 | 0.9 | -1.5 | -2.8 | – | -3.4 | -4.6 | -4.1 | -4.9 | 2.9 | 2.5 | 2.1 | 1.8 | 1.2 | 1.7 |
| Endoplasmic Reticulum | 0 | 0 | 0 | 0 | – | 0 | 0 | 0 | 0 | 0 | 0 | 0 | 0 | 0 | 0 |
| Endosome | 0 | 0 | 0 | 0 | – | 0 | 0 | 0 | 0 | 0 | 0 | 0 | 0 | 0 | 0 |
| Golgi | 0 | 0 | 0 | 0 | – | 0 | 0 | 0 | 0 | 0 | 0 | 0 | 0 | 0 | 0 |
| Mitochondria | 0 | 0 | 3.4 | 0 | – | 3.6 | 3.9 | 4.8 | 5.4 | 0 | 0 | 0 | 0 | 0 | 0 |
| Nucleus | 0 | 0 | 0 | 0 | – | 0 | 0 | 0 | 0 | 0 | 0 | 0 | 0 | 0 | 0 |
| Nuclear Periphery | 0 | 0 | 0 | 0 | – | 0 | 0 | 0 | 0 | 0 | 0 | 0 | 0 | 0 | 0 |
| Nucleolus | 0 | 0 | 0 | 0 | – | 0 | 0 | 0 | 0 | 0 | 0 | 0 | 0 | 0 | 0 |
| Peroxisomes | 0 | 0 | 0 | 0 | – | 0 | 0 | 0 | 0 | 0 | 0 | 0 | 0 | 0 | 0 |
| SpindlePole | 0 | 0 | 0 | 0 | – | 0 | 0 | 0 | 0 | 0 | 0 | 0 | 0 | 0 | 0 |
| Vacuole | 0 | 0 | 1.5 | 3.1 | – | 2.7 | 2.5 | 1.6 | 2.2 | 0 | 0 | 0 | 0 | 0 | 0 |
External localization resources
Images






























Protein Concentration and Protein Localization Data
| R1 | R2 | R3 | ||||||||||||||||
|---|---|---|---|---|---|---|---|---|---|---|---|---|---|---|---|---|---|---|
| G1 Pre-START | G1 Post-START | S/G2 | Metaphase | Anaphase | Telophase | G1 Pre-START | G1 Post-START | S/G2 | Metaphase | Anaphase | Telophase | G1 Pre-START | G1 Post-START | S/G2 | Metaphase | Anaphase | Telophase | |
| Concentration | 9.2203 | 11.7702 | 11.0653 | 10.4769 | 9.9973 | 10.8177 | 13.9799 | 16.803 | 16.091 | 14.2909 | 16.1118 | 15.782 | 15.8295 | 19.1351 | 17.8384 | 14.0176 | 17.5468 | 17.274 |
| Actin | 0.0031 | 0.0011 | 0.0012 | 0.0005 | 0.0002 | 0.0003 | 0.0015 | 0.0009 | 0.0007 | 0.0013 | 0.0006 | 0.001 | 0.0056 | 0.0004 | 0.0005 | 0.0013 | 0.0009 | 0.0009 |
| Bud | 0.0003 | 0.0007 | 0.0018 | 0.0002 | 0.0003 | 0.0001 | 0.0019 | 0.0016 | 0.0021 | 0.0006 | 0.0007 | 0.0004 | 0.0003 | 0.0009 | 0.0013 | 0.0004 | 0.0027 | 0.0002 |
| Bud Neck | 0.0005 | 0.0003 | 0.0003 | 0.0007 | 0.0006 | 0.0012 | 0.0007 | 0.0004 | 0.0008 | 0.001 | 0.0009 | 0.0015 | 0.0004 | 0.0002 | 0.0003 | 0.0005 | 0.0004 | 0.0012 |
| Bud Periphery | 0.0002 | 0.0004 | 0.0009 | 0 | 0.0001 | 0 | 0.0011 | 0.0006 | 0.0009 | 0.0003 | 0.0005 | 0.0004 | 0.0001 | 0.001 | 0.0009 | 0.0001 | 0.0019 | 0.0001 |
| Bud Site | 0.0004 | 0.0043 | 0.0031 | 0.0001 | 0 | 0 | 0.0014 | 0.0019 | 0.004 | 0.0015 | 0.0002 | 0.0001 | 0.0005 | 0.0002 | 0.0002 | 0.0003 | 0.0003 | 0.0001 |
| Cell Periphery | 0.0001 | 0.0001 | 0.0001 | 0 | 0 | 0 | 0.0002 | 0.0001 | 0.0002 | 0.0001 | 0.0001 | 0 | 0.0001 | 0.0001 | 0 | 0.0001 | 0.0001 | 0 |
| Cytoplasm | 0.9344 | 0.9769 | 0.972 | 0.9731 | 0.9819 | 0.9684 | 0.9496 | 0.9575 | 0.9373 | 0.9347 | 0.9639 | 0.9528 | 0.9436 | 0.9858 | 0.9795 | 0.9682 | 0.9798 | 0.9656 |
| Cytoplasmic Foci | 0.0095 | 0.0024 | 0.0016 | 0.0023 | 0.0023 | 0.0024 | 0.002 | 0.0017 | 0.002 | 0.0031 | 0.0016 | 0.0026 | 0.0097 | 0.0009 | 0.0011 | 0.0025 | 0.0011 | 0.0042 |
| Eisosomes | 0 | 0 | 0 | 0 | 0 | 0 | 0 | 0 | 0 | 0 | 0 | 0 | 0 | 0 | 0 | 0 | 0 | 0 |
| Endoplasmic Reticulum | 0.0032 | 0.0007 | 0.0007 | 0.0005 | 0.0008 | 0.002 | 0.003 | 0.0026 | 0.0019 | 0.0023 | 0.0018 | 0.0017 | 0.0028 | 0.0006 | 0.0007 | 0.0046 | 0.0013 | 0.0017 |
| Endosome | 0.0098 | 0.0004 | 0.0004 | 0.0008 | 0.0006 | 0.0015 | 0.001 | 0.0006 | 0.001 | 0.0006 | 0.0009 | 0.0011 | 0.0021 | 0.0003 | 0.0003 | 0.0012 | 0.0004 | 0.0017 |
| Golgi | 0.0029 | 0.0001 | 0.0001 | 0 | 0 | 0 | 0.0001 | 0.0001 | 0.0001 | 0.0001 | 0 | 0.0001 | 0.0015 | 0 | 0 | 0.0001 | 0 | 0.0001 |
| Lipid Particles | 0.0033 | 0 | 0 | 0 | 0 | 0 | 0 | 0 | 0 | 0 | 0 | 0 | 0.0034 | 0 | 0 | 0 | 0 | 0.0001 |
| Mitochondria | 0.0071 | 0.0001 | 0.0001 | 0.0001 | 0.0001 | 0.0001 | 0.0002 | 0.0002 | 0.0002 | 0.0001 | 0.0001 | 0.0001 | 0.0002 | 0.0001 | 0.0001 | 0.0001 | 0.0001 | 0.0001 |
| None | 0.008 | 0.003 | 0.0024 | 0.0018 | 0.0015 | 0.0014 | 0.0058 | 0.0025 | 0.0047 | 0.0048 | 0.0025 | 0.0022 | 0.0099 | 0.0013 | 0.002 | 0.0085 | 0.0017 | 0.0044 |
| Nuclear Periphery | 0.0026 | 0.0011 | 0.0014 | 0.0013 | 0.0014 | 0.0024 | 0.0036 | 0.0029 | 0.0033 | 0.0042 | 0.0025 | 0.0024 | 0.002 | 0.0007 | 0.001 | 0.0024 | 0.0017 | 0.0016 |
| Nucleolus | 0.0001 | 0 | 0 | 0 | 0 | 0 | 0.0001 | 0.0001 | 0.0001 | 0.0001 | 0.0001 | 0 | 0 | 0 | 0 | 0 | 0 | 0 |
| Nucleus | 0.0098 | 0.007 | 0.0128 | 0.0173 | 0.009 | 0.0185 | 0.0248 | 0.0243 | 0.0369 | 0.0411 | 0.02 | 0.031 | 0.0105 | 0.0067 | 0.0111 | 0.0077 | 0.0067 | 0.0148 |
| Peroxisomes | 0.0014 | 0.0001 | 0.0001 | 0.0001 | 0.0001 | 0 | 0.0001 | 0.0001 | 0.0001 | 0.0004 | 0 | 0.0001 | 0.0053 | 0 | 0 | 0 | 0 | 0.0001 |
| Punctate Nuclear | 0.0015 | 0.0008 | 0.0007 | 0.0008 | 0.0003 | 0.0006 | 0.0008 | 0.001 | 0.0015 | 0.0025 | 0.0019 | 0.0015 | 0.0011 | 0.0003 | 0.0003 | 0.0007 | 0.0003 | 0.0017 |
| Vacuole | 0.0013 | 0.0004 | 0.0003 | 0.0003 | 0.0005 | 0.0007 | 0.0018 | 0.0011 | 0.0017 | 0.0012 | 0.0017 | 0.0008 | 0.0007 | 0.0005 | 0.0004 | 0.001 | 0.0005 | 0.0013 |
| Vacuole Periphery | 0.0004 | 0.0001 | 0.0001 | 0.0001 | 0.0001 | 0.0001 | 0.0002 | 0.0001 | 0.0002 | 0.0001 | 0.0002 | 0.0001 | 0.0001 | 0.0001 | 0.0001 | 0.0001 | 0.0001 | 0.0001 |
Sequencing Data
| R1 | R2 | |||||||||
|---|---|---|---|---|---|---|---|---|---|---|
| G1 Post-START | S/G2 | Metaphase | Anaphase | Telophase | G1 Post-START | S/G2 | Metaphase | Anaphase | Telophase | |
| Gene Expression | 259.2218 | 279.823 | 266.0397 | 208.896 | 195.3141 | 238.5476 | 209.9862 | 173.0556 | 194.996 | 189.717 |
| Translational Efficiency | 1.3675 | 1.3028 | 1.3952 | 1.6614 | 1.8059 | 1.4649 | 1.564 | 1.9964 | 1.5511 | 1.7433 |
Hit Data
| Dataset | Hit |
|---|---|
| Protein Concentration | ✘ |
| Protein Localization | ✘ |
| Gene Expression | ✘ |
| Translational Efficiency | ✘ |
Endocytosis
| Temp | Actin Patch (Sac6-tdTomato) | Cortical Patch (Sla1-GFP) | Late Endosome (Snf7-GFP) | Vacuole (Vph1-GFP) |
|---|---|---|---|---|
| 37℃ | ||||
| RT |
Cell Cycle Omics
CYCLoPs (Apt1-GFP)
| Gene / Allele | Actin Patch (Sac6-tdTomato) | Cortical Patch (Sla1-GFP) | Late Endosome (Snf7-GFP) | Vacuole (Sac6-tdTomato) |
|---|
| Gene | Images |
|---|
| Gene | Images |
|---|
Images are not yet available
Images are not yet available